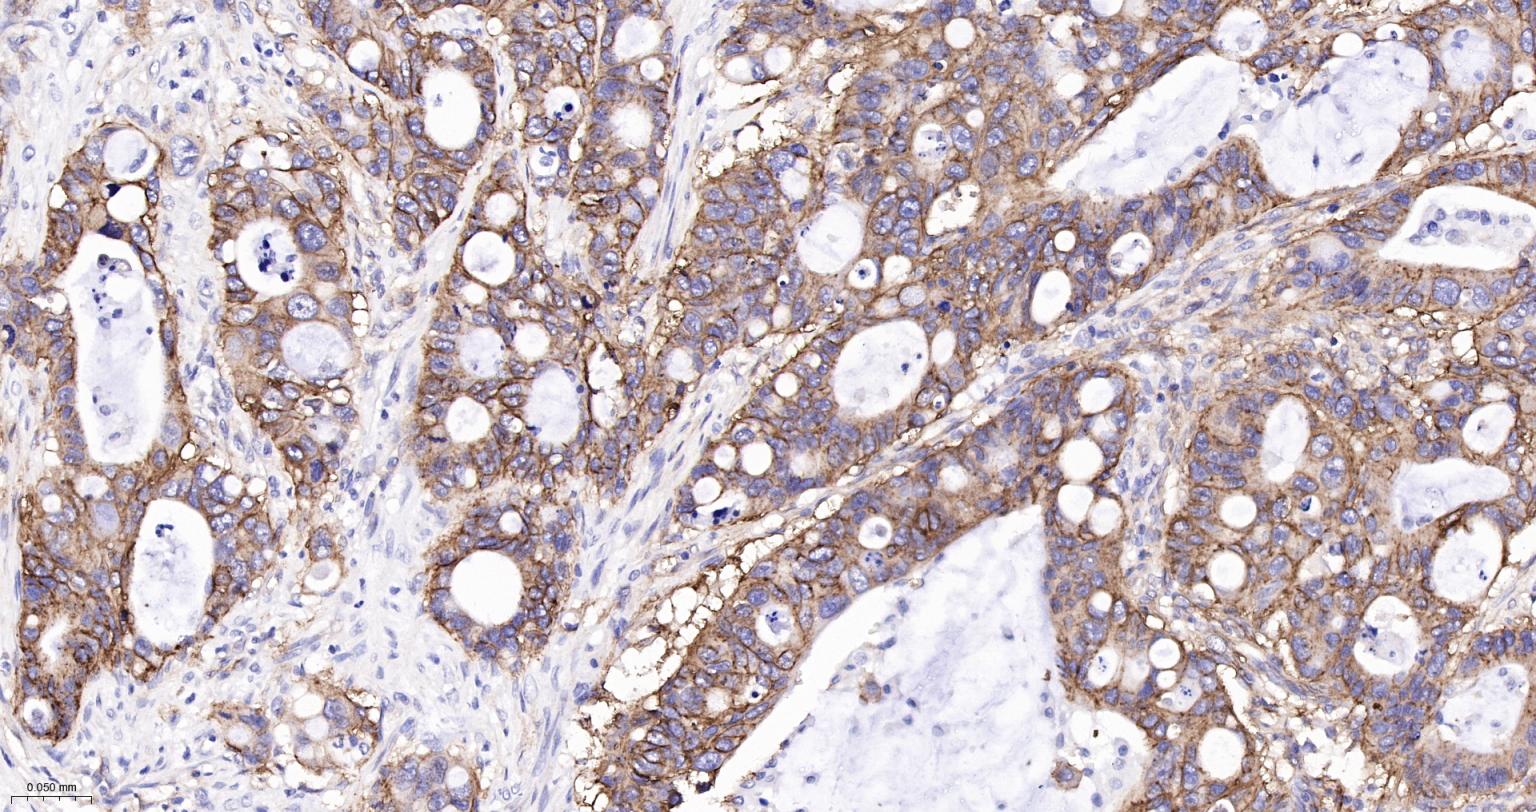
整合素α2（CD49b）重组兔单抗

Integrin alpha 2 Recombinant Rabbit mAb (一抗) - WB,IHC-P,IHC-F,IF,ICC/IF | Bioss
Rrmab?兔单抗

货号:bsm-52613R
产品详情
相关标记
相关产品
相关文献
常见问题
概述
产品编号
bsm-52613R
产品类型
重组兔单抗
英文名称
Integrin alpha 2 Recombinant Rabbit mAb
中文名称
整合素α2(CD49b)重组兔单抗
英文别名
BR; CD49B; FMAIT3; GPIa; HPA-5; VLA-2; VLAA2; DX5; ITA2_HUMAN; ITGA2; CD49 antigen-like family member B; Collagen receptor; Platelet membrane glycoprotein Ia (GPIa); VLA-2 subunit alpha; ITA2_MOUSE;
抗体来源
Rabbit
免疫原
A synthesized peptide derived from human Integrin alpha 2: 1100-1181
亚型
IgG
性状
Liquid
纯化方法
affinity purified by Protein A
克隆类型
Recombinant
克隆号
14D7
理论分子量
127 kDa
检测分子量
150 kDa
浓度
1mg/ml
储存液
0.01M TBS (pH7.4) with 1% BSA, 0.02% Proclin300 and 50% Glycerol.
研究领域
SWISS
Gene ID
保存条件
Store at -20℃ for one year. Avoid repeated freeze/thaw cycles. The lyophilized antibody is stable at room temperature for at least one month and for greater than a year when kept at -20°C. When reconstituted in sterile pH 7.4 0.01M PBS or diluent of antibody the antibody is stable for at least two weeks at 2-4℃.
注意事项
This product as supplied is intended for research use only, not for use in human, therapeutic or diagnostic applications.
数据库链接
背景资料
Enables amyloid-beta binding activity. Predicted to be involved in several processes, including cell surface receptor signaling pathway; positive regulation of cell migration; and positive regulation of cellular component organization. Predicted to act upstream of or within cell adhesion. Located in basal part of cell and external side of plasma membrane. Is expressed in several structures, including alimentary system; brain; cardiovascular system; eye; and genitourinary system. Human ortholog(s) of this gene implicated in several diseases, including Behcet's disease; artery disease (multiple); blood platelet disease (multiple); diabetes mellitus (multiple); and von Willebrand's disease (multiple). Orthologous to human ITGA2 (integrin subunit alpha 2). [provided by Alliance of Genome Resources, Apr 2022]

产品应用
| 应用 | 已检合格种属 | 预测种属 | 推荐稀释比例 |
|---|---|---|---|
| WB | Human, Mouse, Rat | 1:500-2000 | |
| IHC-P | Human, Mouse, Rat | 1:100-500 | |
| IHC-F | Human, Mouse, Rat | 1:100-500 | |
| IF | Human, Mouse, Rat | 1:100-500 | |
| ICC/IF | Human | Mouse, Rat | 1:50-200 |
交叉反应
交叉反应: Human, Mouse, Rat
相关产品
暂无相关产品
靶标
基因名
ITGA2
蛋白名
Integrin alpha-2
亚基
Heterodimer of an alpha and a beta subunit. Alpha-2 associates with beta-1. Interacts with HPS5 and RAB21. Binds to human echoviruses 1 and 8 capsid proteins and acts as a receptor for these viruses. Interacts (via ITAG2 I-domain) with rotavirus A VP4; this interaction only occurs in rotavirus integrin-dependent strains, for which ITGA2 acts as a receptor.
亚细胞定位
Membrane; Single-pass type I membrane protein.
相似性
Belongs to the integrin alpha chain family.
Contains 7 FG-GAP repeats.
Contains 1 VWFA domain.
Contains 7 FG-GAP repeats.
Contains 1 VWFA domain.
功能
Integrin alpha-2/beta-1 is a receptor for laminin, collagen, collagen C-propeptides, fibronectin and E-cadherin. It recognizes the proline-hydroxylated sequence G-F-P-G-E-R in collagen. It is responsible for adhesion of platelets and other cells to collagens, modulation of collagen and collagenase gene expression, force generation and organization of newly synthesized extracellular matrix.
同靶标产品
相关文献
提示: 发表研究结果有使用 bsm-52613R 时请让我们知道,以便我们可以引用参考文章。作为回馈,资料提供者将获得我们送上的小礼品。
具体参考文献:bsm-52613R 被引用于5文献中